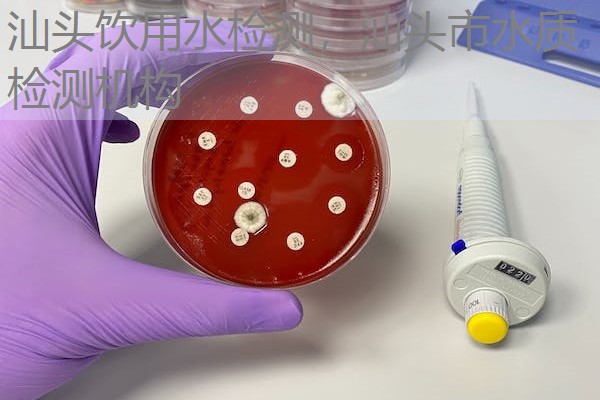
汕头饮用水检测,汕头市水质检测机构 汕头饮用水检测,汕头市水质检测机构

汕头作为广东的重要城市之一,经济快速发展,城市基础设施不断完善,居民的生活水平不断提升,相应的对饮用水安全的关注也日益增强。为保障公众饮水安全,汕头市及相关企业纷纷选择专业的饮用水检测机构进行科学、准确的检测与认证。作为具有权威资质的第三检测认证机构,我们提供全面、多维的汕头饮用水检测服务,旨在帮助企业和公众确保饮用水质量达到国内外标准,保障人体健康与公共安全。
汕头饮用水检测简介
汕头饮用水检测是指采用先进仪器设备和科学检测方法,对饮用水中的各项指标进行分析和评估,确保水质符合国家标准和相关行业规范。饮用水检测不仅是企业生产卫生安全的重要保障,也是市民日常生活的基础保障。检测内容主要涵盖水源水、管网水、饮用水终端水等不同环节,内容包括微生物指标、物理指标、化学指标及重金属指标等。
随着国家对公共饮用水安全的重视提升,我国已制定一系列标准化法规,如《生活饮用水卫生标准》(GB5749-2022)和《饮用水水质标准》(WHO/WHO/2004等国际标准参考),对饮用水的水质提出了详细的指标要求。这些标准明确规定了水中应不含有害微生物、重金属、农药残留,有害物质的检测限量,为检测机构提供了操作依据。我们专业的检测团队依据国家和行业标准,采用国际先进的检测技术,为汕头地区的饮用水安全提供科学依据和保障措施。
汕头饮用水检测服务流程

我们的饮用水检测服务流程科学规范,确保每一份检测报告的准确可靠。主要流程包括:
- 需求咨询与方案设计:客户可通过电话或官网直接咨询检测需求,我们的专业团队将根据客户的实际情况,提供量身定制的检测方案,包括检测项目、检测标准、样品采集要求等。
- 样品采集:由经验丰富的检测人员进行现场抽样,确保样品代表性和采集条件符合标准。采样环节严格遵循国标、行业标准(如《生活饮用水采样方法GB/T 5750.12)),避免二次污染,确保检测数据的真实有效性。
- 样品检测:样品送检后,采用国际先进的仪器设备(如原子吸收光谱仪、气相色谱质谱仪等)进行多项指标检测。检测项目包括细菌总数、大肠杆菌、余氯、pH值、重金属(如铅、镉、汞)、农药残留、挥发性有机物等。检测周期通常为3-7个工作日,具体时间根据检测项目复杂程度而定。
- 检测数据分析与报告:所有检测数据经过专业分析,结合国家标准进行评判。检测报告内容详实,包含检测指标列表、检测结果、是否符合标准、分析建议等,确保客户可以一目了然掌握水质情况。
- 合格证书与后续服务:符合国家及行业标准的水样,将获得检测合格证书,为企业提供认证依据。我们同时提供水质改善建议、后续检测方案等增值服务,帮助客户持续监控水质变化,确保饮用水长期安全。
饮用水检测项目与标准
在饮用水检测过程中,常规检测项目涵盖多项指标,严格依据国家标准和国际协调标准执行。主要检测项目包括:
- 微生物指标:大肠杆菌总数、菌落总数、嗜冷菌群、菌落计数等。根据《生活饮用水卫生标准》(GB5749-2022),大肠杆菌的检测尤为关键,代表水源是否受到粪便污染。
- 化学指标:余氯、pH值、色度、浊度、氟化物、硝酸盐、亚硝酸盐、总硬度、钙镁离子等。依据国家标准,确保饮用水的基本物理和化学安全。
- 重金属检测:铅、汞、镉、砷、铬等指标,严格遵照 GB 5749-2022 和 WHO标准的限量控制。重金属超标会造成严重的健康隐患,因此检测尤为重视。
- 有机污染物:挥发性有机物(如苯、甲苯、二甲苯)以及农药残留等,依据国内外先进标准进行逐项检测,确保水中不含有害有机污染物。
国家标准《生活饮用水卫生标准》(GB5749-2022)及国际规范(如WHO水质指南)为检测提供权威依据。检测结果符合标准即表示水质安全,未达标则需采取整改措施。我们提供的检测服务持续升级,与行业标准同步,以满足不断变化的检测需求。
汕头饮用水检测费用及增值服务
检测费用依据检测项目的复杂程度、样品数量及检测频次而定。一般来说,基础检测套餐价格在合理范围之内,具体报价可通过咨询我们的客服团队获得。我们秉持公开透明原则,确保每一位客户了解费用组成,避免隐藏收费。
我们提供多样的增值服务,包括:
- 专项指标检测:针对特殊水源或特殊需求,进行专项指标分析,如药物残留、放射性物质等。
- 水质改善方案咨询:根据检测结果,提供专业的水质改善建议,帮助企业制定科学的水处理方案。
- 持续监控和跟踪检测计划:为企业提供定期的水质检测与监控,确保水质稳定达标。
- 认证与报告服务:协助企业申请水质安全认证,提供权威检测报告,支持企业商标推广与市场竞争。
我们的价格优势来自高效的检测流程和先进的设备,力求为汕头地区企业和公众提供性价比优异的检测服务,帮助客户实现水质安全的长远保障。
总结
汕头饮用水安全关乎广大市民的健康和城市的良好形象。通过专业的第三检测认证机构进行科学、规范的水质检测,可以有效识别潜在的污染风险,确保饮水水源达标。我们的检测团队拥有丰富的行业经验,严格遵循国家和国际标准,提供全面、准确、可靠的检测结果和技术支持。无论是企业需要获得水质合格证,还是城市基础设施方进行水质监控,我们都能提供一站式解决方案,助力汕头市实现持续的水质安全保障。
欢迎咨询我们,获取最新的检测项目、标准解读及价格信息,让我们共同为汕头的美好水环境贡献力量!











